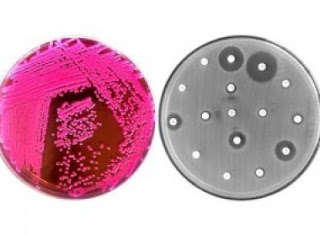

Pesquisadores do Instituto de Ciências Biomédicas da Universidade de São Paulo (ICB-USP) identificaram, pela primeira vez no Brasil, o gene mcr-1, que causa resistência a uma classe de antibióticos utilizados para tratar infecções por bactérias multirresistentes. O gene foi encontrado em cepas da bactéria Escherichia coli isoladas de animais de produção. Os responsáveis pela identificação da bactéria super rersistente, já identificaram o primeiro caso de infecção humana no Brasil, em um hospital de alta complexidade em Natal (RN), por uma cepa da bactéria portadora do gene e resistente a Colistina (polimixina E), um dos mais poderosos antibióticos, considerados como último recurso no tratamento de infecções produzidas por bactérias que não respondem a outras drogas. “A aparição desse gene no Brasil pode contribuir para o surgimento de bactérias totalmente resistentes aos antibióticos, com risco de enfrentarmos uma situação similar ao que foi a era pré-antibiótica, quando doenças comuns, como uma infecção urinária ou um ferimento profundo na pele, levavam facilmente a óbito”, alerta Nilton Lincopan, responsável pela. A bactéria foi identificada recentemente na China e em países da Europa, da Ásia e da África.